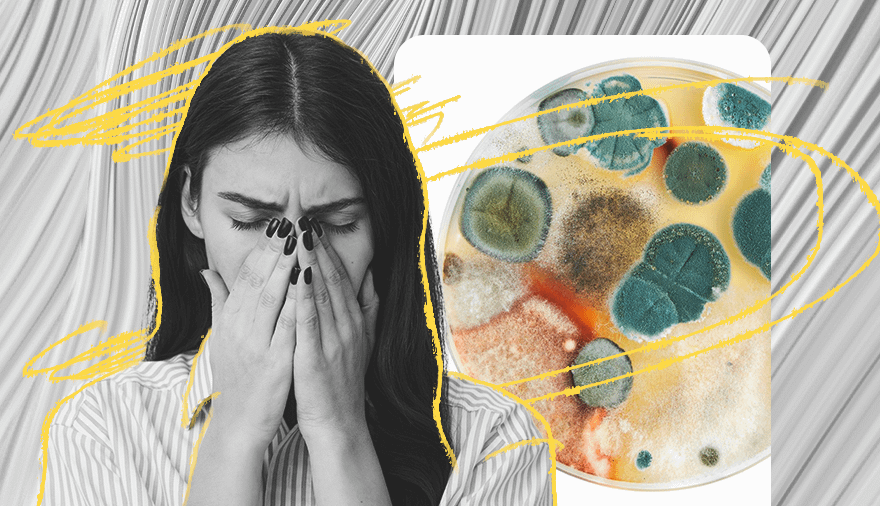

При этом здоровый организм может легко противостоять этим факторам, а вот тем, кто страдает от хронических заболеваний, осенью стоит обратить на здоровье особое внимание. О том, какие заболевания чаще всего обостряются осенью и с чем это может быть связано, подробнее рассказываем в материале.
1. Болезни желудочно-кишечного тракта
Чаще всего в осенне-зимний период обостряются язвенная болезнь желудка и двенадцатиперстной кишки. Нередко самочувствие в начале осени ухудшается и у тех, кто страдает от панкреатита, дуоденита и гастрита. Особенно если человек не занимается лечением и не следит за питанием.
Если ты замечаешь, что осенью у тебя часто появляются боли в желудке и в животе, обратись к специалисту. Врач назначит тебе обследование и предложит курс эффективной именно для тебя терапии.
2. ОРВИ
Острая респираторная вирусная инфекция — это общее название группы заболеваний, протекающих с поражением верхних дыхательных путей и общей интоксикацией. В народе под ОРВИ чаще всего подразумевают простуду, которую подхватывают как раз в осенне-зимний период.
Среди самых распространенных симптомов простуды выделяют высокую температуру, кашель, а также насморк и боли в горле. Неприятное состояние также сопровождается потерей аппетита, ознобом и ломотой в теле.
Чтобы как можно скорее выздороветь, важно придерживаться рекомендаций врача и соблюдать постельный режим. О том, какие ошибки могут ухудшить твое состояние при простуде, читай здесь.
3. Аллергия на плесень
Осенью в подвалах, санузлах и других помещениях с высоким уровнем влажности появляется плесень. Этот грибок хорошо растет во влажной среде и может быть очень опасным для организма.
Кстати, осенью плесень может размножаться и под открытым небом. Она появляется на опавшей листве и загнивающих растениях, а ее споры летают в воздухе.
Чтобы снизить риск появления аллергии на плесень, как можно чаще проветривай помещения, в которых проводишь много времени и избавься от всех предметов, которые пахнут плесенью. И не забывай хотя бы раз в неделю проводить влажную уборку.
4. Холодовая аллергия
Аллергия на холод — еще одна проблема, которая чаще всего проявляется осенью и зимой. Она может стать причиной покраснения, зуда кожи и образования волдырей. В редких случаях аллергия на холод может спровоцировать отек Квинке. Чтобы разобраться, почему именно возникает аллергия, нужно проконсультироваться с аллергологом. Он выпишет антигистаминные препараты и подскажет, как избежать повторного появления аллергии.
О том, как еще проявляется холодовая аллергия и что делать, чтобы избавиться от нее, подробнее читай в материале.
5. Цистит
На почве переохлаждения также может возникнуть и цистит — воспалительный процесс в мочевыводящих путях.
Чтобы избежать возможных проблем, старайся всегда одеваться по погоде и не забывай прикрывать живот и поясницу на холоде. Не менее важно не откладывать поход в уборную и ежедневно пить достаточное количество чистой воды.
6. Депрессия
Плохая погода, холод, нехватка солнечного света: все эти погодные факторы у чувствительных людей с лабильной психикой могут спровоцировать возникновение или обострение депрессии.
Так называемую сезонную депрессию связывают с нарушениями обмена серотонина — вещества, которое отвечает за наше настроение. К числу факторов, которые также повышают риск развития сезонной депрессии, относят:
- тяжелые болезни;
- эмоциональную возбудимость;
- хроническое переутомление;
- наследственную предрасположенность.
Чтобы избежать появления сезонной депрессии, старайся восполнять недостаток серотонина. Следи за балансом витаминов в организме, ешь больше фруктов и овощей, соблюдай режим дня. Доказано, что занятия спортом и прогулки в дневное время также улучшают настроение. А также помогают избежать возникновения депрессии или облегчить ее симптомы.
7. Остеоартрит
С приходом осени многие люди также сталкиваются с болями в суставах — острее проявляются хронические заболевания и зарождаются новые. Ученые предполагают, что подобное происходит из-за снижения атмосферного давления, повышенного уровня влажности и понижения температуры воздуха.
К счастью, избежать появления остеоартрита все же можно. Для этого нужно выполнять упражнения, полезные для суставов, носить теплую одежду и при необходимости заранее начать прием лекарств, которые поддерживают здоровье хрящей.